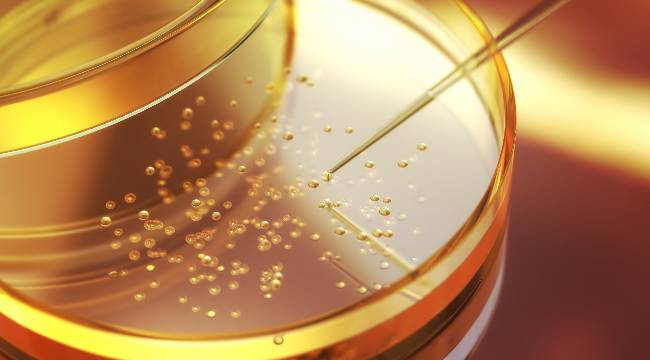

Bilaloğlu, AA muhabirine, plastik ürünlerin hem çevreye hem de insan sağlığına karşı çeşitli riskler barındırdığı için insanların çeşitli arayışlara girdiğini söyledi.
Özellikle son dönemde, plastik pipetlerden uzak durmak isteyen kişilerin ilk olarak kağıt pipetlere yöneldiğini ifade eden Bilaloğlu, bunların sıvıyla temasta daha dayanıksız olduğu için cam pipetlere olan ilginin arttığına işaret etti.

Cam pipetlerin yanı sıra cam eşyaların sağlık açısından zararı bulunmamasına karşın dikkatli kullanılması gerektiğini vurgulayan Bilaloğlu, "Yıkama sırasında, rafa yerleştirirken, bulaşık makinesine koyarken ya da bardakta bir içeceği karıştırırken göremediğimiz, başta fark edemediğimiz mikro çatlaklar oluşabiliyor. Bu çatlaklar da sonradan içtiğimiz içecekle beraber ağız yoluyla sindirim sistemimize girebiliyor." ifadelerini kullandı.
Bilaloğlu, çatlakları çocukların fark edemeyebileceğini belirterek, sözlerini şöyle sürdürdü:
"Erişkinler belki yaralanmadan fark edebilir ama çocuklarda bunun bilinci çok olmadığı için sıkıntılı durumlar ortaya çıkabilir. Ağız içi yaralanmalar, dil yaralanmaları, ağız içi kesiler yapabilir. Onun dışında sindirim kanalının her seviyesinde yaralanma riski olan bir ürün. Yemek borusunda, midede, ince bağırsakta, kalın bağırsakta herhangi bir seviyede takılabilir. Burada kanamaya neden olabilir. Bu organlarda delinmeye neden olabilir. Buna bağlı ameliyat ihtiyacına kadar gidebilir."
3 "Küçük yaştaki çocuklar cam ürünlerle yalnız bırakılmamalı"

Sadece pipet değil, cam ürünlerin tamamında çocukların dikkatli olması gerektiğine değinen Bilaloğlu, "Özellikle gözetimsiz ve küçük yaştaki çocuklar cam ürünlerle yalnız bırakılmamalı. İnce cam bardaklar ve ince cam pipetleri dişleriyle kırıp yutabilirler. Bu da aynı riski doğuruyor ya da bardakla çocuğu yalnız bıraktık ve kırdı. Dışarıdan parça alıp ağzına atabiliyor. Hatta oral dönemdeki çocuklarımız için yine aynı riskler mevcut." diye konuştu.












